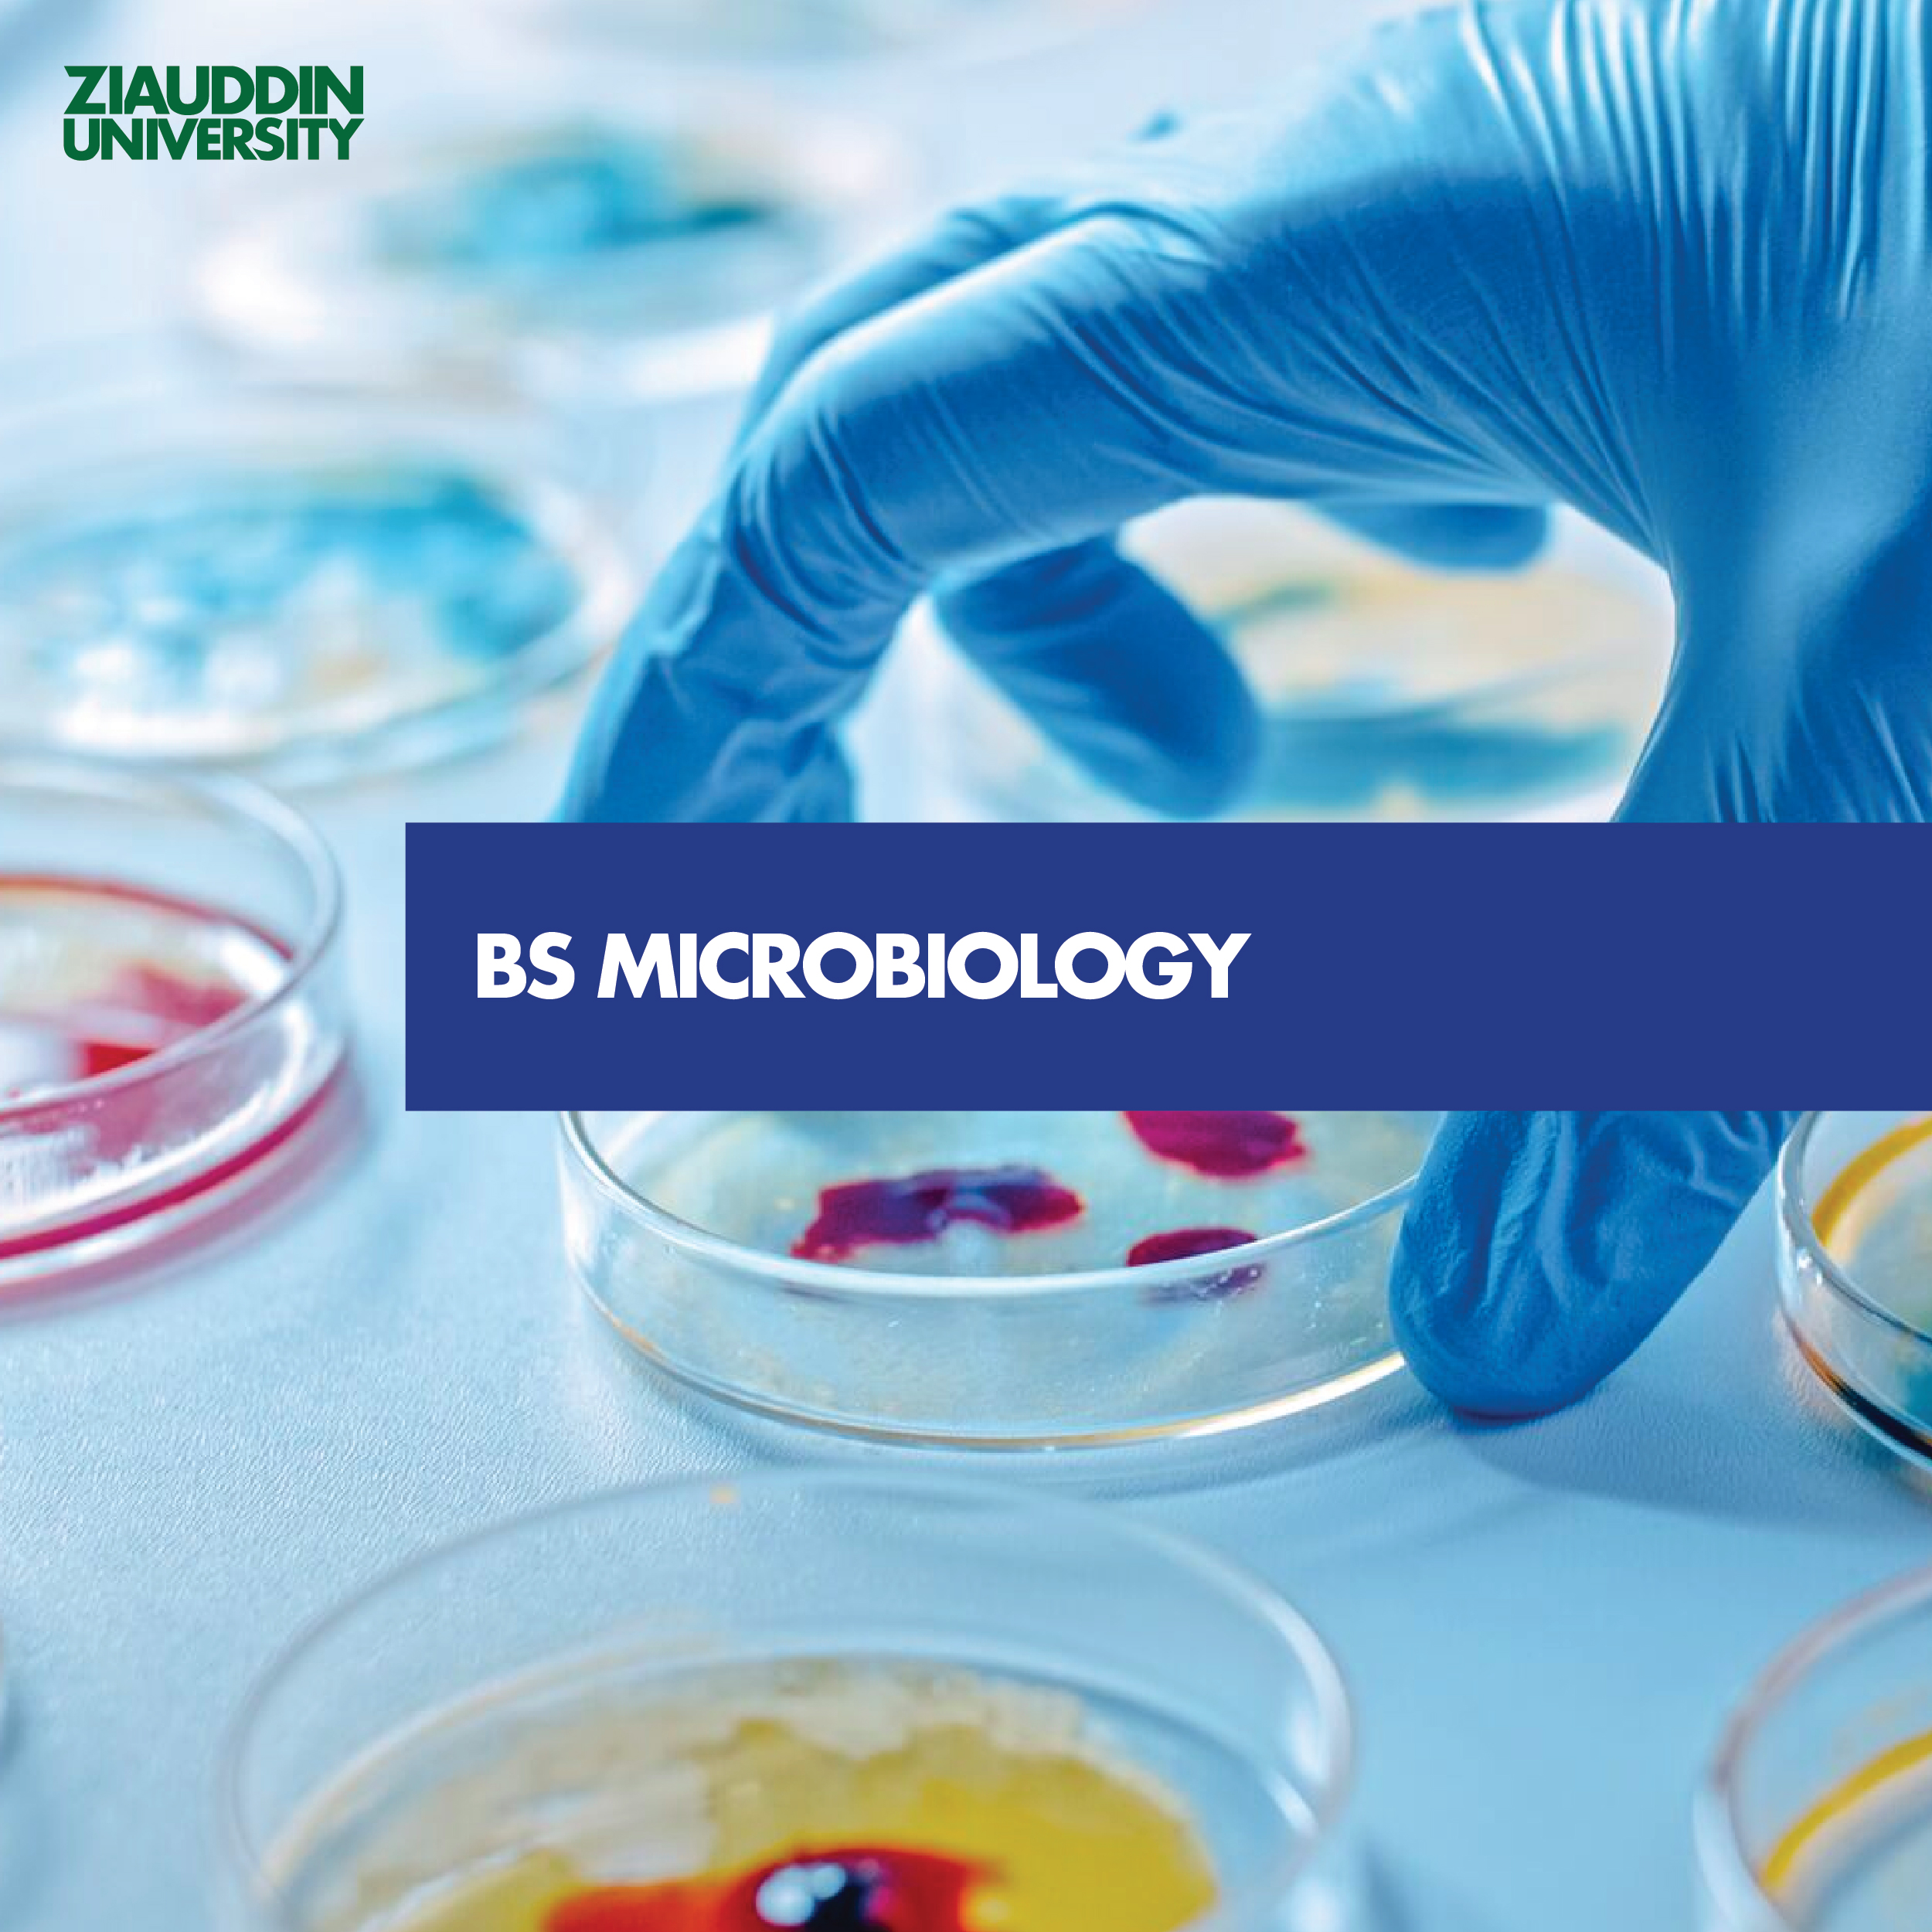

Faculty of Engineering , Science, Technology & Management
- Introduction
- Departments
- Programmes
- Career Opportunities
- Faculty
- News and Events
Since Ziauddin University has been running the College of Biomedical Engineering for the last nine years, and after sustaining and consolidating this engineering unit, we’ve evolved and expanded. As per the directives of the worthy Chancellor, the knowledge areas of Engineering, Science, Technology and Management are being integrated into the Ziauddin University Faculty of Engineering, Science, Technology & Management (ZUFESTM). This integration will enable us to offer Bachelor’s, Master’s, and PhD degree programmes with full consent and consultation from the concerned regulators.
ZUFESTM aims to develop as a “contributing community” than just an academic unit. We are focused to provide an environment where faculty, students and staff should be motivated ambitious and willing workers. Our goal is to create strong bonds, encouraging future alumni to actively support and propel the growth and development of their alma mater.
The leadership of ZU recognizes that an organization’s inner strength lies in its human resources. Therefore, capacity building of existing manpower and attracting a new highly qualified workforce is the prime focus of ZUFESTM. The highly qualified faculty is committed to supporting the organization’s vision and mission. ZUFESTM is dedicated to becoming known for its innovative pedagogic approach, integrating interactive learning tools and case study-based teaching, and fostering a research environment where studies are conducted with a greater purpose than mere publication. ZUFESTM aims to emerge as one of the most responsive research units, addressing upcoming opportunities and social issues.
In the pursuit of opening new horizons, ZUFESTM aims to launch programmes in line with market needs. Our objective is to produce graduates in disciplines with high job scopes. ZUFESTM graduates will highlight an entrepreneurial attitude, emphasizing market leadership over job seeking.
Exploring unchartered waters of knowledge to make the world a better place to live.
To acquire, promote, advance and disseminate knowledge of engineering, sciences, technology and management, and to apply this knowledge to enhance the quality of life through research to empower generations with the necessary skills, leadership qualities, and attitudes to excel as professionals, while fostering interactions with industry, government and community for the sustainable advancement of humankind.
Engineering Programmes
- BE Civil Engineering
- BS Electrical Engineering
- BE Biomedical Engineering
Computing Programmes
- BS Software Engineering
- BS Data Science
Technology Programmes
- BS Biotechnology (AgTech)
- BS Electrical Technology (Evening)
- BS Civil Technology (Evening)
- BS Biomedical Equipment Technology
Management Programmes
- BS Management & Technology (Morning)
- BBA (Morning)
- Finance, Marketing, Banking, HRM, Economics, Information Technology, Hotel Management
Postgraduate Programmes
- MS Electrical Engineering (Telecommunication, Automation & Control, Computer Networks & Data Communication)
- Ph.D. Electrical Engineering
- Master of Business Administration (MBA)
- Ph.D. (Management Sciences)
- Ph.D. Civil Engineering
Undergraduate Programmes
Postgraduate Programmes
Engineering Science, Technology and Management is a field of education that offers job prospects in areas that help build a successful society. The career opportunities available for students studying Engineering Science, Technology and Management are vast. The job opportunities in each field of study offered at Ziauddin University Faculty of Engineering Science, Technology and Management include:
Applied Physics: Career options include Aerospace engineer, Astronomer, Automotive Engineer, Biochemist and Biophysicist, Biomedical engineer, Electrical engineering technologist, Nuclear engineer etc.
Architecture: Interior and spatial designer, Town planner, Historic buildings inspector, Structural Engineer, and Architect.
Biomedical Engineering: Biomaterials developer, Manufacturing engineer, Independent consultant, Doctor, Biomedical scientist/researcher, Rehabilitation engineer, Medical technology developer etc.
Electrical Engineering: Control and instrumentation engineer, Design engineer, Electrical engineer, Electronics engineer, IT consultant, Network engineer, Nuclear engineer, Sound engineer, Special effects technician etc.
Civil Engineering: Building control surveyor, Consulting civil engineer, Design engineer, Estimator, Nuclear engineer, Site engineer, Structural engineer, Water engineer etc.
Software Engineering: Code developer, Communications specialist, Embedded software engineer, Financial analyst, IT specialist, Mobile software engineer, Research and development consultant, Technology Writer, Video Game Developer, Website Designer etc.
Data Science: Machine learning engineer, Data Scientist, Data architect, Data engineer, Business intelligence developer, Data analyst etc.
Electrical Technology: Engineer in the energy sector, Electronics engineer, Naval engineer, Automotive engineer, Aerospace engineer, Oil and gas engineer, Medical engineer etc.
Civil Engineering Technology: Construction manager, Geotechnical engineer, Environmental engineer, Public health engineer. Transportation engineer, Urban planning engineer etc.
Science Management and Technology: Biomedical engineering and technology, Bioinstrumentation, Biomaterials, Biomechanics, Clinical engineering, Medical Imaging, Orthopedic bioengineering, Rehabilitation engineering etc.
Biotechnology: Biochemist, Bioinformatician, Biophysicist, Biomedical engineer, Biotechnology/Pharmaceutical sales. Biotechnology laboratory technician, Crime lab technician, Environmental engineer etc.
Business Administration: Marketing executive, Business development executive, Sales executive, Human resource manager, Market research analyst, Marketing manager, Finance manager etc.
Dean

Engr. Prof. Dr. Fahad Azim, PE
MBA, Ph.D., MSC, BE
Professors

Engr. Prof. Dr. Abdul Aziz Ansari
Ph.D. (Structural Engineering), ME (Structural Engineering), BS (Civil Engineering)

Engr. Dr. Sheikh Muhammad Munaf
Ph.D. (Artificial Intelligence and Computer Vision). MS (Telecommunication), BS (Electronic Eng)

Dr. Saad Jawaid Khan
Ph.D. (Biomechanics), ME (Biomedical Engineering), BE (Biomedical Engineering)
Associate Professors

Engr. Dr. Samia Tariq
Ph.D.(Civil Engineering), MSc (Building Engineering), BSc (Building & Architectural Engineering)

Dr. M. Yousuf Irfan Zia
Ph.D. (Electrical, Telecommunication Engineering), MS (Computer Engineering), BS (Electronic Engineering)

Dr. Syed Faraz Jawed
Ph.D. (Biomaterials), ME (Biomedical Engineering), BE (Biomedical Engineering)

Abdul Nasir Qureshi
Associate Professor / HOD M. Arch, NED UET, Pakistan B. Arch, NED UET, Pakistan Architecture & Environmental Design
Assistant Professors

Dr. Fariha Ibrahim
Ph.D. (Biotechnology), MS (Microbiology), BS (Microbiology)

Dr. Syeda Bushra Zafar
Ph.D. (Biotechnology) , M.Sc. (Biotechnology), B.Sc. (Physiology)

Engr. Mehwish Faiz
Ph.D. (In Progress), ME (Electronics Engineering), BS (Biomedical Engineering)

Engr. Hira Zahid
Ph.D. (In Progress), ME (Electronics Engineering), , BS (Biomedical Engineering)

Engr. Ali Asghar
Ph.D. (In Progress), ME (Biomedical Engineering), , BE (Biomedical Engineering)

Mushtaque Ali
Ph.D. in Progress, M.Arch, MUET, B. Arch, CEAD

Engr. Rehan Adil
MS (Controls and Automation) , BS (Electronic Engineering)

Dr. Saifullah
Ph.D. (Finance), MPhil (Finance), MBA (Finance)

Dr. Nazia Keerio
Ph.D. (Technology Management) Malaysia, MBA (HRM)

Ar. Jamzadi Lalarukh
M. Arch., B. Arch.

Rabia Siddiqui
Assistant Professor (Visiting Faculty) Architecture & Environmental Design M. Sc. Loughbourah University UK. B. Arch. DUET
Senior Lecturers

Sania Zafar
MBA (Human Resource), BBA (Marketing)

Engr. Muhammad Kamran
ME (Construction Management), BS (Civil Engineering)

Engr. Ashfaque Ahmed
Ph.D. (Energy Systems Engineering) , ME (Electrical Engineering), BE (Electrical Engineering)

Engr. Sumaira Ismail
ME
Lecturers

Syed Ghazanfar Ali
MBA (Marketing), B.Com

Engr. Mohsin Khan
ME (Computer Engineering), BE (Computer System Engineering)

Engr. Jahanzaib sherani
ME (Transportation Engineering), BS (Civil Engineering)

Engr. Owais Memon
ME (Electrical Engineering), BE (Electrical Engineering)

Engr. Kashif Rafique Memon
MS (Construction Management), BE (Civil Engineering)

Engr. Muhammad Asjad Alam
MBA (Marketing), MS (Structures), BS (Civil Engineering)

Rabia Bibi
M.Arch, B. Arch

Engr. Amad Ali
ME (Electrical Engineering) , BE (Electrical Engineering)

Engr. Muhammad Usaid
MS (Electrical Engineering), BE (Electrical Engineering)

Syed Rashid Ali
Ph.D. (Economics), MPhil (Economics), MSc (Economics)

Engr. Sabeen Manzoor
MS (Structural Engineering), NEDUET, Karachi, Pakistan BS (Civil Engineering), NEDUET, Karachi, Pakistan
Studio Architect

Azizullah Khan
Architecture & Environmental Design
Lab Engineers

Engr. Taha Mushtaq
BS (Biomedical Engineering)

Engr. Dhanik Vikrant
ME (Water Resource Engineering), BE (Civil Engineering)

Engr. Alyas Khan mandokhail
ME (Water Resources Engineering), BS (Civil Engineering)

Engr. Shahbaz Ahmed
MS (Cyber Security), BS (Electrical Engineering)

Engr. Taha Mushtaq Shaikh
MBA (Healthcare Management), BE (Biomedical Engineering)

Engr. Sana Rehan
ME (Biomedical Engineering), BE (Biomedical Engineering)

Engr. Syed Hassan Sarwar
MS (In Progress), BE (Biomedical Engineering)

Engr. Syeda Iqra Hassan
MS (Electrical Engineering), BS (Electronic Engineering)

Engr. Syed Mudassir Ahmed
BS (Electrical Engineering)

Engr. Muhammed Arsalaan
BS (Electrical Engineering)

Engr. Muzammil Nayyar
MS (Electrical Engineering), BS (ElectricalEngineering)
Lab Engineers

Muhammad Anus
Lecturer - Software Engineering Department

Abdul Salam
NCBC (Lab)

Syeda Iqra Hassan
Click here for News & Events
- About us
- Departments
- Programmes
- Faculty
ZU has been running College of Biomedical Engineering for last nine years. After sustaining and consolidating an engineering unit now it’s time to grow and expand. As per the directives of worthy Chancellor the Engineering Science and Technology knowledge areas are being integrated as Ziauddin University Faculty of Engineering Science & Technology (ZUFEST) to offer Bachelor, Master & PhD degree programs with full consent and consultation of concerned regulators.
ZUFEST aims to develop as a “contributing community” than just an academic unit. We are focused to provide an environment where faculty, students and staff should be motivated ambitious and willing workers. The bonding should be such that future Alumni themselves take lead to help their alma mater grow & develop.
Leadership of ZU is mindful of the fact that inner strength of any organization lies with its Human Resource. Therefore, Capacity building of existing manpower and attracting new highly qualified workforce is prime focus of ZUFEST. The highly qualified faculty is on board to support the Vision& Mission of the organization. ZUFEST is striving hard to be known for its different pedagogic approach equipped with interactive learning tools & case study based teaching and a research base where research is conducted for a bigger purpose than just a publication. ZUFEST targets to emerge as one of the most responsive research unit to upcoming opportunities and social issues.
Moving forward in the pursuit of opening up new horizons, ZUFEST is aiming to launch programs in line with the market needs. Our objective is to produce graduates in the disciplines which are not saturated hence having high job scopes. Entrepreneurial attitude shall be the highlight of ZUFEST graduates. They should have potential to be the market leaders than just a job seeker. Currently, ZUFEST embraces Departments of Civil Engineering, Electrical Engineering, Biomedical Engineering and Software Engineering. This year ZUFEST is introducing a new department of Management Technology & Information Sciences which will offer BS Management & Technology and BBA. Moreover, DBME is also introducing two new programs namely BS Biotechnology and BS Biomedical Equipment Technology.
ZUFEST is successfully running BS Software Engineering (NCEAC recognized), BS Civil Engineering, BS Electrical Engineering, BE Biomedical Engineering (with due recognition from Pakistan Engineering Council) & BS Electrical Technology programs. After getting the partnership in establishing first ever National Center for Big Data & Cloud Computing, ZUFEST is launching BS Data Science under the umbrella of Department of Software Engineering in coming academic year.
In a nutshell, ZUFEST has following programs to offer:
Engineering Programs
- BS Civil Engineering
- BS Electrical Engineering
- BE Biomedical Engineering
Computing Programs
- BS Software Engineering
- BS Data Science
Technology Programs
- BS Biotechnology (AgTech)
- BS Electrical Technology (Evening)
- BS Civil Technology (Evening)
- BS Biomedical Equipment Technology
Management Programs
- BS Management & Technology (Morning)
- BBA (Morning)
- Finance, Marketing, Banking, HRM, Economics, Information Technology, Hotel Management
Postgraduate Programs
- MS Electrical Engineering (Telecommunication, Automation & Control, Computer Networks & Data Communication)
- PhD Electrical Engineering
Mission
The faculty mission is to acquire, promote, develop and disseminate knowledge of engineering, sciences, technology, management, and its application to improve the quality of life and, in particular, to equip present and future generation with skills and attitudes to attain competence as professionals and to interact with industry and community for sustainable development of humankind.
Vision
Ziauddin University Faculty of Engineering, Science, Technology & Management (ZUFESTM) envisions itself as a leading academic institution that produces graduates with an entrepreneurial mindset, capable of becoming market leaders in the fields of Civil, Electrical, Biomedical, Software Engineering and Management Technology & Information Sciences. Our aim is to provide an innovative and interactive learning environment, promoting capacity building and research-based teaching. We are committed to attracting and retaining highly qualified faculty, staff and students, while fostering a culture of motivation, ambition and willingness to work. ZUFESTM aspires to be a responsive research unit that tackles social issues and emerging opportunities. By continuously expanding and launching new programs in line with market needs, ZUFESTM is determined to produce competent professionals, equipped with the skills and knowledge required to contribute to the growth and development of society.
Undergraduate Programmes
Postgraduate Programmes
International Programmes (UNIVERSITY OF NORTHAMPTON, UK)
Dean

Engr. Prof. Dr. Fahad Azim, PE
MBA, PhD, MSC, BE
Professors

Engr. Prof. Dr. Muhammad Asif
PhD (Electrical Engineering, Control), MS (Electrical Engineering), BS (Biomedical Engineering),

Engr. Prof. Dr. Abdul Aziz Ansari
PhD (Structural Engineering), ME (Structural Engineering), BS (Civil Engineering)

Engr. Dr. Sheikh Muhammad Munaf
Ph.D. (Artificial Intelligence and Computer Vision). MS (Telecommunication), BS (Electronic Eng)
Associate Professors

Engr. Dr. Samia Tariq
PhD (Civil Engineering), MSc (Building Engineering), BSc (Building & Architectural Engineering)

Dr. M. Yousuf Irfan Zia
PhD (Electrical, Telecommunication Engineering), MS (Computer Engineering), BS (Electronic Engineering)

Dr. Saad Jawaid Khan
PhD (Biomechanics), ME (Biomedical Engineering), BE (Biomedical Engineering)

Dr. Syed Faraz Jawed
PhD (Biomaterials), ME (Biomedical Engineering), BE (Biomedical Engineering)

Abdul Nasir Qureshi
Associate Professor / HOD M. Arch, NED UET, Pakistan B. Arch, NED UET, Pakistan Architecture & Environmental Design
Assistant Professors

Dr. Fariha Ibrahim
PhD (Biotechnology), MS (Microbiology), BS (Microbiology)

Dr. Syeda Bushra Zafar
PhD (Biotechnology) , M.Sc. (Biotechnology), B.Sc. (Physiology)

Engr. Mehwish Faiz
PhD (In Progress), ME (Electronics Engineering), BS (Biomedical Engineering)

Engr. Hira Zahid
PhD (In Progress), ME (Electronics Engineering), , BS (Biomedical Engineering)

Engr. Ali Asghar
PhD (In Progress), ME (Biomedical Engineering), , BE (Biomedical Engineering)

Muhammad Afzal Brohi
M.Arch, MUET, B. Arch, MUET.

Mushtaque Ali
Ph.D. in Progress, M.Arch, MUET, B. Arch, CEAD

Engr. Rehan Adil
MS (Controls and Automation) , BS (Electronic Engineering)
Senior Lecturers

Sania Zafar
MBA (Human Resource), BBA (Marketing)

Mr. Arif
PhD (In Progress), M.Ed. (Education), M.Phil. (Environmental Biotechnology), M.Sc. (Microbiology), B.Sc. (Microbiology)

Engr. Muhammad Kamran
ME (Construction Management), BS (Civil Engineering)

Engr. Ashfaque Ahmed
PhD (Energy Systems Engineering) , ME (Electrical Engineering), BE (Electrical Engineering)
Lecturers

Syed Ghazanfar Ali
MBA (Marketing), B.Com

Engr. Nazia Ejiaz
PhD (In Progress), ME (Biomedical Engineering),BS (Biomedical Engineering)

Engr. Mohsin Khan
ME (Computer Engineering), BE (Computer System Engineering)

Ar. Jamzadi Lalarukh
M. Arch., B. Arch.

Engr. Jahanzaib sherani
ME (Transportation Engineering), BS (Civil Engineering)

Engr. Owais Memon
ME (Electrical Engineering), BE (Electrical Engineering)

Engr. Sobhan Shakeel
MS (Biomedical Engineering), BE (Biomedical Engineering)

Ms. Sanober Kafeel
M.Phil. (Biotechnology), M.Sc, (Zoology)

Engr. Kashif Rafique Memon
MS (Construction Management), BE (Civil Engineering)

Engr. Muhammad Asjad Alam
MBA (Marketing), MS (Structures), BS (Civil Engineering)

Rabia Bibi
M.Arch, B. Arch

Bilawal Sathio
M.Arch, B. Arch

Engr. Amad Ali
ME (Electrical Engineering) , BE (Electrical Engineering)

Engr. Muhammad Usaid
MS (Electrical Engineering), BE (Electrical Engineering)
Studio Architect

Azizullah Khan
Architecture & Environmental Design
Lab Engineers

Engr. Taha Mushtaq
BS (Biomedical Engineering)

Engr. Tamima Imtiaz
BS (Biomedical Engineering)

Engr. Dhanik Vikrant
ME (Water Resource Engineering), BE (Civil Engineering)

Engr. Alyas Khan mandokhail
ME (Water Resources Engineering), BS (Civil Engineering)

Engr. Shahbaz Ahmed
MS (Cyber Security), BS (Electrical Engineering)

Engr. Taha Mushtaq Shaikh
MBA (Healthcare Management), BE (Biomedical Engineering)

Engr. Shaheer Mirza
MS (In Progress), BE (Biomedical Engineering)

Engr. Sana Rehan
ME (Biomedical Engineering), BE (Biomedical Engineering)

Engr. Syed Hassan Sarwar
MS (In Progress), BE (Biomedical Engineering)

Engr. Syeda Iqra Hassan
MS (Electrical Engineering), BS (Electronic Engineering)

Engr. Syed Mudassir Ahmed
BS (Electrical Engineering)

Engr. Muhammed Arsalaan
BS (Electrical Engineering)

Engr. Muzammil Nayyar
MS (Electrical Engineering), BS (ElectricalEngineering)
Lab Engineers

Ms. Batool Hasan
BS (Biotechnology)

Ms. Anamta Zia
BS (Biotechnology)

Muhammad Anus
Lecturer - Software Engineering Department

Abdul Salam
NCBC (Lab)

Syeda Iqra Hassan